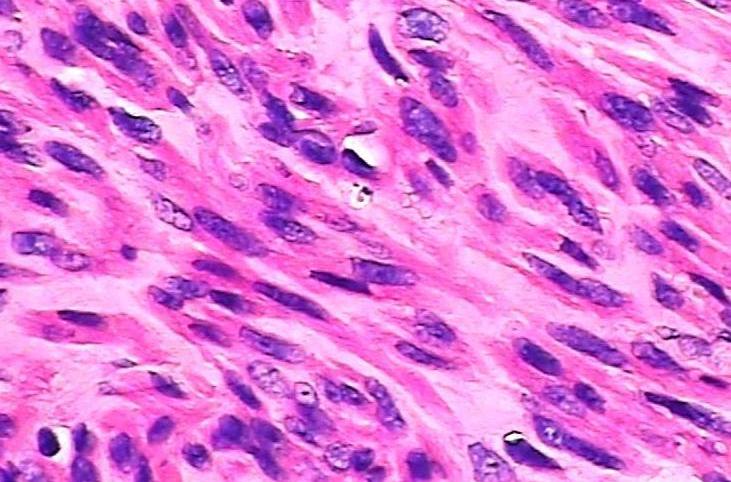
苏木精-伊红染色

伊红染色

苏木精-伊红染色
图片尺寸731x482
诊断外科病理学苏木素-伊红(he)染色之奇妙色彩(一)
图片尺寸616x458
伊红染液(醇溶)染液-赛维尔生物服务|产品_servicebi
图片尺寸1000x1000
伊红染色液(醇溶)
图片尺寸4000x4000
伊红曙红染色液eosiny2
图片尺寸850x850
苏木精—伊红染色
图片尺寸3357x3132
图4. 肺活检标本(苏木精-伊红染色)
图片尺寸1200x2766
久聚和苏木素伊红染色液苏木精伊红染色he染色液 2×500ml 科研实验
图片尺寸800x800
苏木素伊红(he)染色试剂盒
图片尺寸850x850
伊红染色液
图片尺寸2275x3875
诊断外科病理学苏木素-伊红(he)染色之奇妙色彩(一)
图片尺寸404x304
苏木精伊红染色法hematoxylineosinstaininghe染色法
图片尺寸502x376
图5he伊红染色×400,病理为巨淋巴结增生症
图片尺寸620x490
伊红染色不均匀原因
图片尺寸697x748
求助he染色
图片尺寸4000x3000
化妆品中耐热大肠菌群检测
图片尺寸1080x1440
淋巴结染色不正常 2016-05-17 10:33 关注 我做了好几次淋巴结
图片尺寸612x816
诊断外科病理学苏木素-伊红(he)染色之奇妙色彩(一)
图片尺寸635x480
最近做的脂肪干细胞的诱导分化,油红0染料成脂和茜素红染色成骨.
图片尺寸1360x1024
诊断外科病理学苏木素-伊红(he)染色之奇妙色彩(一)
图片尺寸452x340